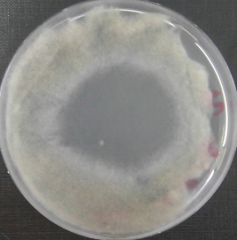

Projekte
Molekulare Mykologie und Mykoparasitismus
Trichoderma atroviride and its secondary metabolites
Similar to other fungi, mycoparasitic Trichoderma species are prolific producers of secondary metabolites which comes along with a variety of secondary metabolism-associated genes in their genomes. There are direct and indirect evidences in favor of involvement of secondary metabolites in the antagonistic activity of Trichoderma against a considerable number of bacteria, yeasts, and fungi as well as in the beneficial effects Trichoderma exerts on crop plants. Many of the genes involved in secondary metabolism are part of large biosynthetic gene clusters comprising core enzymes such as non-ribosomal peptide synthetases (NRPSs), polyketide synthases (PKSs), or terpene synthases/cyclases, accessory enzymes (like cytochrome P450s, oxidoreductases, methyl transferases, etc.), and, in some cases, genes for transporters and transcription factors.

Comparison of the numbers of secondary metabolism-associated genes and gene clusters encoded in the genomes of three different Trichoderma species (from Zeilinger et al., 2016; Fungal Biology Reviews 30, pp. 74-90)
Trichoderma-derived secondary metabolites comprise non-ribosomal peptides such as peptaibiotics, siderophores and diketopiperazines-like gliotoxin and gliovirin, polyketides, terpenes, pyrones (such as 6-pentyl-alpha-pyrone, 6-PP), and isocyane metabolites. However, it has to be borne in mind that the production of these substances is species- and even strain-dependent and not the whole repertoire will be biosynthesized by a given fungus under laboratory conditions as specific triggering stimuli may be required. In this project, we functionally characterize selected genes and gene clusters involved in secondary metabolite biosynthesis and assess their contribution to the antagonistic activity of Trichoderma mycoparasites. Furthermore, the chemical cross-talk by small molecules during the fungus-fungus interaction will be exploited for triggering metabolite production.
